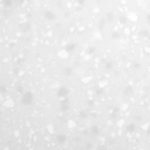

Dental Cabinetry Range
Our cabinetry ranges are designed and manufactured in the UK, combining performance-led construction with refined, contemporary finishes.
Each range is compatible with our full selection of worktops and can be tailored to suit your space, workflow, and clinical requirements.
Avon Range
Warm. Architectural. Timeless.

Stone Grey Gloss

Light Grey Gloss

Gunmetal Grey Gloss

Cashmere Gloss

Black Gloss

Dust Grey Gloss

Cream Gloss

Frost White Gloss
Trent Range
Clean. Contemporary. Refined.

Anthracite Grey Metallic

Beige Metallic

Metallic Blue

Caramel Matt

Black Matt

Stone Grey Matt

Heritage Green Matt

Indigo Matt
Eden Range
Bold. Distinctive. Modern.

Light Grey Matt

Cashmere Matt

Denim Matt

Dust Grey Matt

Dusty Pink Matt

Frost White Matt

Graphite Matt

Alby Blue Matt

Reed Green Matt

Rust Red Matt
Worktop Choices Available
Please Call 0121 559 3737 For Samples
Range A

Temp Grey

Pure White

Latona Lite

Fog
Range B

Antarctic Ice

Frost Land
Frost Quartz

Snow Range
Range C

Black Pepper

French Roast

Gold Twilight

Rainy Sky
